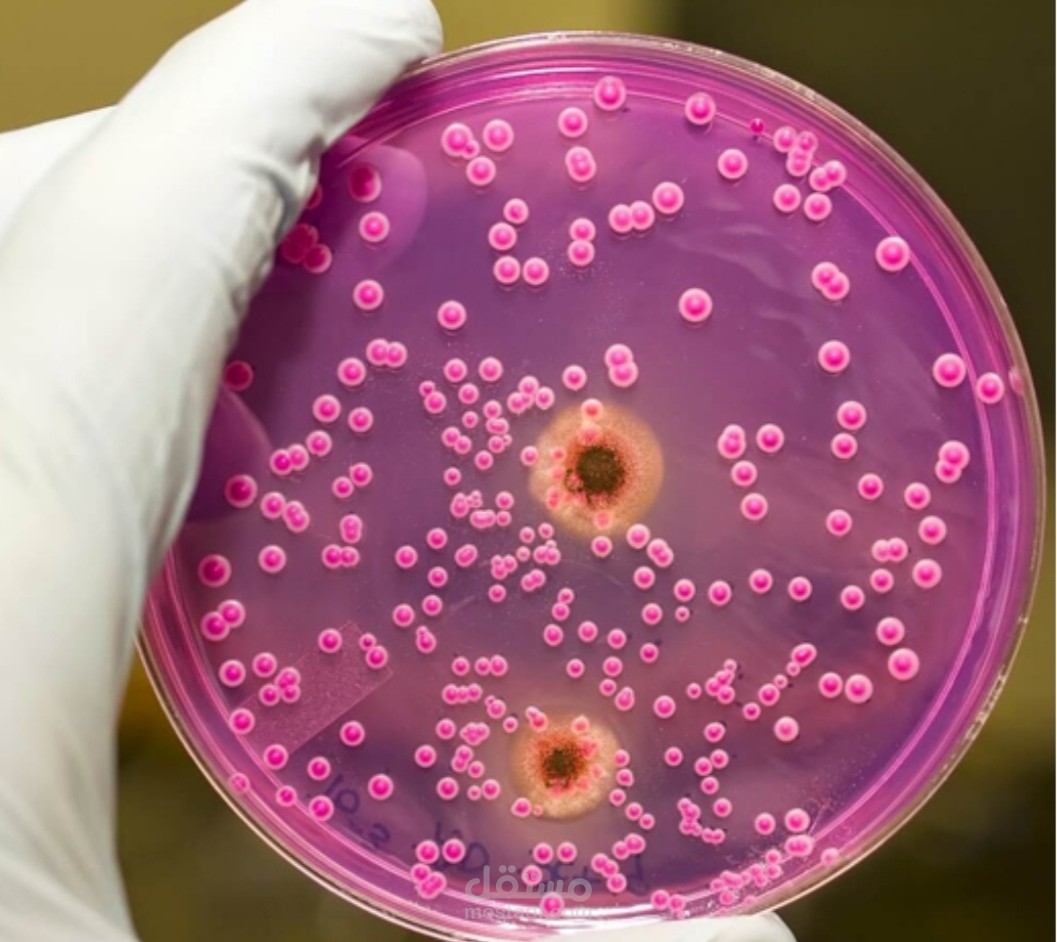
مقال متوسط الطول عن البكتريا

Nora M.
نبذة عني
كاتبه ومترجمه محنك يتمتع بخبرة تزيد عن 4 سنوات في صياغة مقالات جذابة وغنية بالمعلومات وترجمه النصوص والمقالات اللغه الانكليزيه. مع شغف برواية القصص وعين حريصة على التفاصيل ، شحذ مهاراتي لتقديم محتوى عالي الجودة يأسر القراء. ثق فيي لإحياء أفكارك من خلال الكلمات.